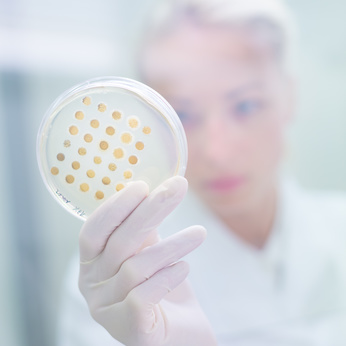

Qualitätskontrolle
Getragen von der Philosophie des Lean Six Sigma beschränken wir uns nicht nur auf mikrobiologische Prüfungen, Sichtprüfungen, Eingangs- oder Endkontrollen. Diese sind selbstredend obligatorisch. Darüber hinaus sind unsere Prozesse so gestaltet, dass sie alle ständigen Kontrollen unterliegen und bei Abweichungen untersucht werden. So steigern wir unsere Effizienz – das schont unseren und auch den Geldbeutel unserer Kunden, und das Ganze bei gleichzeitiger Gewährleistung von hoher Qualität und Sicherheit. Bei jedem Schritt erfolgen Prüfungen bis hin zu Inprozesskontrollen, speziell für die Kontrolle der Ph-Werte und der Viskosität. Nicht zuletzt wird unser Qualitätsmanagement durch die externe Zertifizierung laufend bestätigt.
Noch ein Wort zu Standards: Wir garantieren die GMP-konforme Qualitätssicherung. In unserem gut ausgestatteten Labor garantieren wir eine Qualitätssicherung auf höchstem Niveau. Einfach „state of the art“!
Ein immer mehr wachsender Teil des Qualitätsmanagements ist der Bereich der Dokumentation und Nachverfolgbarkeit. Wir dokumentieren den gesamten Herstellungsprozess nach den Vorgaben der Kosmetik GMP/ISO 22716 und entsprechend der EU-Verordnung 1223/2009 in der jeweils gültigen Fassung – begonnen bei der Rohstoffanlieferung bis zum Versand, in unserem und im Interesse unser Kunden.
